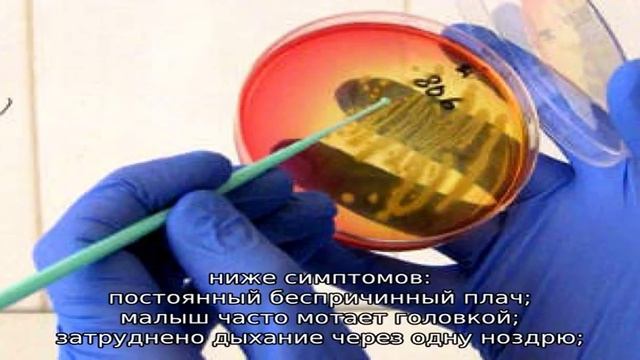
Этмоидит: симптомы и лечение у детей смотреть онлайн

Автор / Канал: Формирование и эстетика бровей Страница 5

Тестируем Помаду для бровей от Орифлэйм

EYEBROW MICROBLADING ANIMATION // Kylie Eyebrow Inspiration

Ариана Фролова читает произведение «Мне нравится, что Вы больны не мной...» М. И. Цветаевой

Перманентный макияж обучение

Маркер для бровей 43986 Орифлэйм

Макияж губ матовые помады Мэри Кей Mary Kay

ЧТО В МОЕЙ СУМОЧКЕ? ЧТО В СУМКЕ У БЛОГЕРА ?

Юрий Шулипа правда о значении проекта Елены Васильевой в 2014 году

Di_rubens проверяет Лëву на психику

Spanien-Tour 2023?? #7 Ab ans Meer?️➡️Costa Brava ☀️Roses & Sant Pere Pescador

РАСХЛАМЛЕНИЕ | Как я психанула и избавилась от кучи косметики

На сколько важна борода в ИСЛАМЕ

FIND YOUR SHADE: Anastasia Beverly Hills Powder Bronzer

Макияж на Хеллоуин ❤️

Eyelash lift & tinting

В этом году Буйнакский район отмечает вековой юбилей.

"Ребят, это не надо снимать"

Разработка приложения под Android с нуля(Часть 6)
Этмоидит: симптомы и лечение у детей

ПРИКОЛ ПОПУГАЙ УЛАМЫВАЕТ ЦЫПЛЁНКА

Тейпирование лица - патчи и лимфодренаж (1 этаж)

Мои небольшие покупочки для себя и дома

How to fill in sparse eyebrows using the Benefit brow collection

Проекты в SingularityApp: для чего нужны и как с ними работать
За каждым успешным каналом стоит личность, идея и сотни часов кропотливого труда. Если вы здесь, значит, автор «Формирование и эстетика бровей» уже сумел зацепить ваше внимание своим уникальным стилем или подачей. А мы на RUVIDEO позаботились о том, чтобы вы могли изучить весь архив его работ в максимально комфортных условиях — без лишней суеты и преград.
Почему за работами канала «Формирование и эстетика бровей» так интересно наблюдать? Всё просто: это честный контент, который находит отклик в сердцах зрителей. На нашем ресурсе вы можете смотреть онлайн все видео любимого автора бесплатно и в хорошем качестве. Нам важно, чтобы вы видели каждую деталь и слышали каждый нюанс, поэтому мы используем только стабильные плееры из открытых источников Rutube.
Следите за новинками канала, пересматривайте старые шедевры и открывайте для себя новые грани творчества «Формирование и эстетика бровей». Мы постоянно обновляем ленту, чтобы у вас под рукой всегда были самые свежие выпуски. Никаких сложных регистраций — только вы и творчество, которое вдохновляет. Приятного вам путешествия по миру авторского контента на RUVIDEO!
Видео взято из открытых источников Rutube. Если вы правообладатель, обратитесь к первоисточнику.